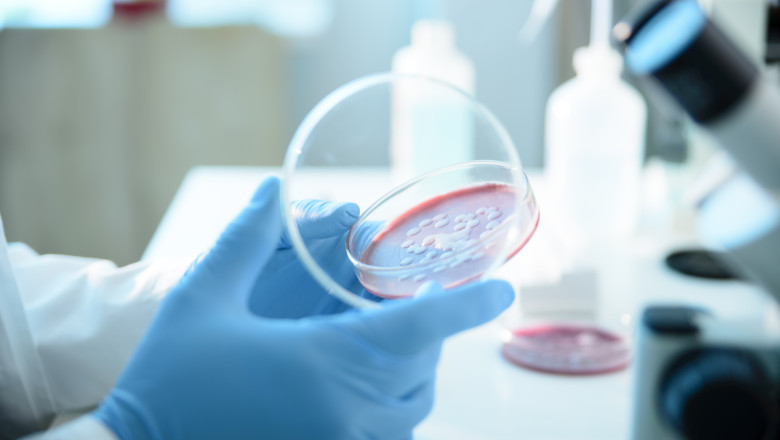
Ce este Serratia marcescens, bacteria descoperita la Spitalul „Sfanta Maria” din Iasi, unde au murit sase copii Imagine

Direcţia de Sănătate Publică (DSP) Iaşi a început o anchetă epidemiologică la Spitalul de Copii „Sfânta Maria” privind un posibil focar de infecţii cu o bacterie, după ce șase copii au murit în ultimele zile în secţia de Terapie Intensivă.
„Serratia marcescens este o bacterie pe care o știm de foarte multe vreme, a fost descoperită prin anul 1819 în Italia. Nu se găsește numai în România, ci o găsim oriunde la nivelul globului. Apare în mediul înconjurător, o găsim în plante, în sol, pe spații umede. Problema apare în momentul în care, această bacterie, care este una oportunistă, determină o infecție la nivelul unui pacient vulnerabil. Și aici vorbim, în primul rând, de cei aflați în secțiile de terapie intensivă.
Acele persoane se confruntă deja cu boli cronice sau afecțiuni complexe și au un sistem imunitar fragil, aflat la limita rezistenței. În astfel de situații, Serratia marcescens poate declanșa infecție asociată asistenței medicale (așa-numitele infecții nosocomiale) și poate duce la o infecție generalizată, adică sepsis, care poate, realmente, să ducă la complicații și chiar la deces, din păcate.”, a explicat pentru Digi24 Adrian Marinescu, medic infecționist și managerul Institutului de Boli Infecțioase „Matei Balș” din Capitală.
Serratia marcescens se transmite prin contactul direct cu o persoană infectată, dar și prin contact cu suprafețele care sunt contaminate/echipamente medicale (asta este valabil pentru orice alt microorganism). De cele mai multe ori, persoanele se infectează cu bacteria în spitale sau în centre de îngrijire pe termen lung.
Serratia marcescens poate provoca:
Simptomele depind de localizarea infecției, iar cel mai important pas este diagnosticarea infecției prin analize de laborator (de sânge, analize care presupun prelevarea probelor, dacă vorbim de o infecție cutanată, probă urinară etc). Ulterior, medicul specialist va stabili dacă este vorba despre infecție activă sau infecție generalizată.
Unele simptome generale pot include:
„Serratia marcescens este greu de tratat, pentru că există rezistență în fața medicamentelor/tratamentului. Important de precizat este faptul că trebuie să existe un diagnostic rapid. În cazul infecției văd două probleme: Dacă e să ne gândim, în primul rând, la prevenție, ar trebui să pot preveni apariția infecției mai ales în acele secții de terapie intensivă. Și dacă, totuși, infecția a apărut, contează modalitatea în care am grijă să previn transmiterea ei mai departe în așa fel încât să nu apară focare și să fie mai greu de intervenit.
În concluzie, este foarte important să previn o astfel de infecție. Odată instalată, boala este mult mai dificil de tratat, mai ales atunci când afectează mai mulți pacienți vulnerabili, inclusiv copii.”, conchide medicul infecționist Adrian Marinescu
(Tratamentul infecțiilor cu Serratia marcescens se face cu antibiotice, însă această bacterie poate dezvolta rezistență la unele dintre ele. Medicul poate solicita analiza unei probe pentru a identifica antibioticul cu cea mai bună eficiență.)
Potrivit Ministerului Sănătății: „Din datele medicale existente la momentul de față, puse la dispoziția Ministerului Sănătății, nu putem realiza o legătură directă, din punct de vedere medical, între infecțiile asociate asistenței medicale, celelalte patologii, comorbidități ale pacienților și deces. Legătura de cauzalitate dintre infecția cu Serratia Marcescens și deces va fi stabilită de experții în medicină legală.”